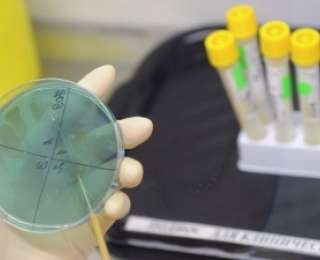

Aroxj.am-ը գրում է․
Aroxj.am-ը գրում է․
Տարբեր մասնագետների կարծիքները, թե առաջիկայում հակաբիոտիկները կորցնելու են իրենց ներուժը և մարդու օրգանիզմն ու նորանոր բակտերիաներն ու վիրուսները չեն կարողանալու հաղթահարել ստիպեց մի խումբ գիտնականների ստեղծել են նոր պրեպարատ: Այն, ըստ մասնագետների, ավելի հզոր է, քան սովորական հակաբիոտիկները և կարողանում է պայքարել <<նոր>> վիրուսների ու բակտերիաների դեմ:
Ամբողջական հոդվածը կարող եք կարդալ այստեղ
Կայքում տեղ գտած մտքերն ու տեսակետները հեղինակի սեփականությունն են և կարող են չհամընկնել BlogNews.am-ի խմբագրության տեսակետների հետ:
print
Տպել



